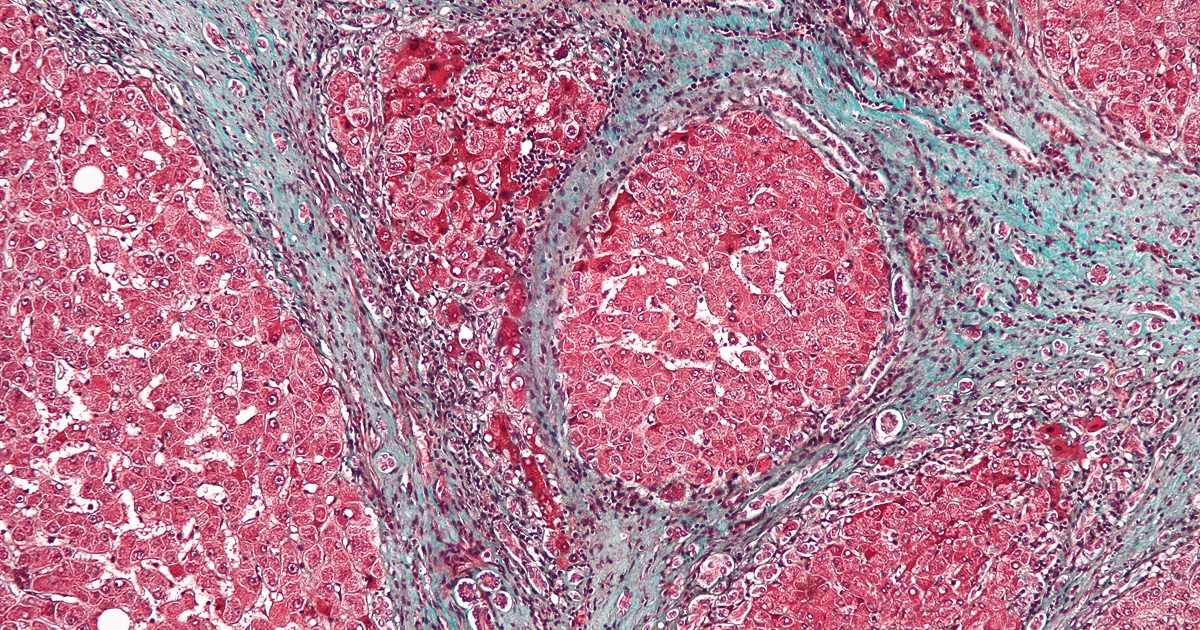

Smrteľné ochorenie pečene si spájame aj s obezitou, cukrovkou, hepatitídou typu B a C či s vysokým cholesterolom. Nový výskum spoločnosti Keck Medicine z USC však naznačuje, že v hre môže byť aj ďalší vinník – chemikália prítomná v čistiacich prostriedkoch, ktorá výrazne zvyšuje riziko vzniku vážnej diagnózy.
Ide o látku tetrachlóretén (PCE), známu aj ako perchlóretylén či tetrachlórethylén. Tradične sa používa ako rozpúšťadlo a nachádza sa v mnohých čistiacich prípravkoch: v lepidlách na remeselné výrobky, v odstraňovačoch škvŕn či v leštidlách na nehrdzavejúcu oceľ, píše SciTechDaily.
Spojili ju so závažným ochorením pečene
Podľa zistení vedcov mali ľudia vystavení PCE trojnásobne vyššie riziko vzniku závažnej fibrózy pečene: ochorenia, ktoré môže prerásť do rakoviny pečene, zlyhania orgánu alebo smrti. Výskum tiež potvrdil jasný trend: čím vyššia miera expozície, tým väčšie riziko.
„Táto štúdia, prvá svojho druhu, ktorá skúma súvislosť medzi hladinami PCE v ľudskom tele a rozvojom fibrózy pečene, poukazuje na prehliadanú úlohu environmentálnych faktorov v zdraví pečene,“ uviedol Brian P. Lee, hepatológ a špecialista na transplantácie z Keck Medicine a hlavný autor štúdie.
„Zistenia naznačujú, že vystavenie PCE môže byť dôvodom, prečo sa u jednej osoby vyvinie ochorenie pečene, zatiaľ čo u niekoho s rovnakým zdravotným a demografickým profilom nie,“ dodal. Výsledky vedci publikovali v Liver International.
Vzduch, oblečenie alebo kontaminovaná pitná voda
Ľudia sa dnes s chemikáliou najčastejšie stretávajú prostredníctvom vzduchu – napríklad, keď sa z chemicky vyčisteného oblečenia uvoľňuje do ovzdušia.
PCE sa však môže dostať aj do pitnej vody, najmä v oblastiach, kde došlo k rozliatiu alebo nesprávnej likvidácii látky. Tá totiž preniká do pôdy a následne do podzemných vôd. Podobné prípady kontaminácie už zaznamenali aj na Slovensku. V roku 2017 Výskumný ústav vodného hospodárstva (VÚVH) pri analýze vzoriek zo studne v blízkosti skládky vo Vrakuni identifikoval štvornásobne prekročené hladiny tetrachlóreténu oproti povoleným limitom pre pitnú vodu.
Medzinárodná agentúra pre výskum rakoviny (IARC) klasifikovala tetrachlóretén ako karcinogén skupiny 2A – teda „pravdepodobne karcinogénny pre človeka“. Okrem najnovších zistení o poškodení pečene ho vedci v minulosti spojili aj s rakovinou močového mechúra, mnohopočetným myelómom (zriedkavá forma rakoviny) a non-Hodgkinovým lymfómom (skupinou zhubných ochorení lymfatickej sústavy).
Vyšší príjem v domácnosti zvyšuje riziko
Zaujímavé je, že vyššie riziko vystavenia PCE hrozí ľuďom z domácností s vyššími príjmami. Práve tí totiž častejšie využívajú služby chemického čistenia. Zvýšenému riziku čelia aj zamestnanci práčovní a čistiarní, ktorí s látkou prichádzajú do kontaktu pravidelne.

„Pacienti sa často pýtajú: Ako môžem mať ochorenie pečene, keď nepijem alkohol a nemám žiadne typické rizikové faktory?“ hovorí Lee. „Odpoveďou môže byť práve vystavenie sa tejto chemikálii.“
Vedci zdôrazňujú, že PCE nemusí byť jediným vinníkom. „Niet pochýb o tom, že v našom prostredí existujú aj iné toxíny, ktoré môžu byť pre pečeň nebezpečné,“ dodáva Lee. „Dúfame, že náš výskum pomôže lekárom aj verejnosti lepšie pochopiť súvislosť medzi vystavením PCE a fibrózou pečene. Ak sa u ľudí s preukázanou expozíciou podarí ochorenie odhaliť včas, dá sa účinnejšie liečiť.“
Budú na Deň boja za slobodu a demokraciu otvorené obchody? Pozrite sa, ako to bude po novom. Toto sme tu dlho nemali
Aby prežili, museli sa uchýliť ku kanibalizmu a jesť svojich kamarátov. Letecké nešťastie v Andách šokuje aj dnes
Adam bol v jednom z vlakov, ktoré sa zrazili: Prišla obrovská rana, nastal chaos. Okolo hlavy mi preletel hasiaci prístroj
Ivana žije v Austrálii: Minimálna mesačná mzda tu je niečo málo cez 2 000 eur pred zdanením, každý si vie slušne zarobiť
Odborník vysvetľuje nehodu vlakov: K zrážke by pravdepodobne nedošlo, ak by systém ETCS mali oba rušne
Mohol to byť animák, jedlo na pľaci smrdelo: 10 vecí, ktoré ste nevedeli o filme Harry Potter a Kameň mudrcov
Najnebezpečnejšia žena bola posadnutá sexom a vraždila mužov pre zábavu. Mamička varí lacné jedlá, aby šetrila peniaze
Bývalý kriminalista Vachálek nám prezradil, ako dolapil vraha Ondreja Riga: Bol to tupec. Kvapôčky krvi nestihol zahladiť
Režisér filmu Veľký vlastenecký výlet: Šokovalo ma, keď pri masovom hrobe zaznelo, že je to „fake“. Koniec je kľúčový













Nahlásiť chybu v článku